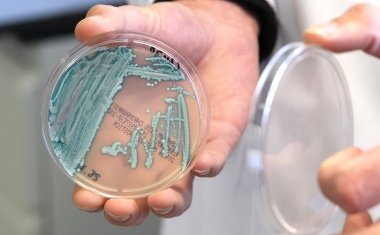
Photo

Die Wilhelm Sander-Stiftung bestätigt zwei ihrer Mitglieder im Wissenschaftlichen Beirat
Die Mandate von Prof. Dr. Ralf Bartenschlager und Prof. Dr. Wolfgang Kastenmüller wurden verlängert. Beide renommierte Wissenschaftler engagieren sich seit mehreren Jahren in dem beratenden Gremium, das die Stiftung bei der Auswahl und Bewertung ihrer Forschungsförderung unterstützt.